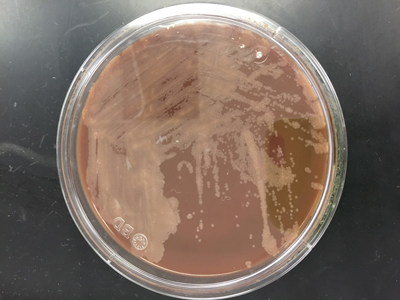
mycofort3

Case History
A 47 year old Caucasian female presented to her primary care physician with a three day history of fever (Tmax 102°F), chills and generalized body aches. Her rapid influenza test was negative, but she was treated with oseltamivir for suspected viral infection. Her past medical history was significant for severe mitral regurgitation for which she had had a prosthetic valve replacement two years prior, ischemic cardiomyopathy with recent pacemaker placement one month prior and an undifferentiated connective tissue disease. Her current medications included hydroxychloroquine (Plaquenil) and warfarin. Her symptoms persisted and upon return to clinic, a urinalysis was performed and blood cultures were collected. On physical exam, the pacemaker site was erythematous and tender to palpation. She was started on doxycycline and fluconazole for a presumed urinary tract infection. After 4 days of incubation on the automated instrument, the two aerobic blood cultures bottles were positive and the patient was admitted to the hospital for further workup and therapy.
Laboratory Identification
Microscopic examination from the positive blood culture bottle revealed slender, beaded Gram positive bacilli (Figure 1). No definitive branching was identified. Given the morphology on Gram stain, a Kinyoun stain was performed and revealed red-purple, beaded acid fast bacilli which were consistent with a Mycobacterium spp. (Figure 2). A Mycobacterial Growth Indicator Tube (MGIT), a Lowenstein Jensen slate and blood & chocolate agars were inoculated with specimen. Given that the organism grew after 2 days, a rapidly growing Mycobacterium spp. was suspected (Figure 3). High performance liquid chromatography (HPLC) identified the organism as M. fortuitum.

Figure 1. Gram stain from the positive blood culture bottle showed slender, beaded Gram positive bacilli that were arranged in clumps (100x oil immersion).

Figure 2. Kinyoun stain of the organisms was consistent with acid fast bacilli (100x oil immersion).
Figure 3. Small, off-white colonies grew on chocolate agar after 3 days of incubation at 35°C in a CO2 incubator.
Discussion
M. fortuitum is a common rapid growing mycobacterial species that is ubiquitous in the environment and tap water. Most common infections due to M. fortuitum include post-traumatic or post-surgical wound infections and it can be associated with the insertion of prosthetic devices including heart valves, artificial joints and rods inserted after fractures. Of the rapid grower group (Runyon Group IV), which includes M. chelonae, M. abscessus and M. mucogenicum, it is M. fortuitum that accounts for approximately 60% of localized cutaneous skin infections and prosthetic device infections most frequently.
In the laboratory, M. fortuitum typically grows after two to five days incubation and appear as small, off-white colonies on a variety of different agars. The organism is typically slender, beaded Gram positive bacilli on Gram stain and positive for acid fast bacilli on a Ziehl-Neelsen or Kinyoun stain. As part of a traditional lab work up, M. fortuitum is arylsulfatase positive and is capable of reducing nitrates. Today a variety of methods, including HPLC, pyrosequencing, sequence analysis and matrix assisted laser desorption ionization time of flight mass spectrometry (MALDI-TOF MS), have become routine identification options. Susceptibility testing of isolates from clinically significant sites should be performed by broth microdilution and includes the following antimicrobials: amikacin, cefoxitin, ciprofloxacin, moxifloxacin, clarithromycin, doxycycline, linezolid, imipenem, meropenem, minocycline, trimethoprim-sulfamethoxazole and tobramycin.
In the case of our patient, it was discovered her pacemaker site was infected and upon further questioning it was discovered she wasn’t able to complete her antibiotic course after device placement due to nausea. A transesophageal echocardiogram showed no evidence of infective endocarditis and she was taken to the operating room for removal of the pacemaker and leads. The site was filled with pus and wound cultures obtained during surgery were consistent with M. fortuitum as well. Repeat blood cultures were negative and she was treated with intravenous amikacin and imipenem as well as oral levofloxacin for an anticipated 6-8 weeks before transitioning to oral therapy.
-Debbie Rigney Walley, MD, is a 1st year Anatomic and Clinical Pathology Resident at the University of Mississippi Medical Center.

-Lisa Stempak, MD, is an Assistant Professor of Pathology at the University of Mississippi Medical Center in Jackson, MS. She is certified by the American Board of Pathology in Anatomic and Clinical Pathology as well as Medical Microbiology. She is the director of the Microbiology and Serology Laboratories. Her interests include infectious disease histology, process and quality improvement and resident education.
Empirical therapy option to start doxycycline and fluconazole for uti is not recommended,